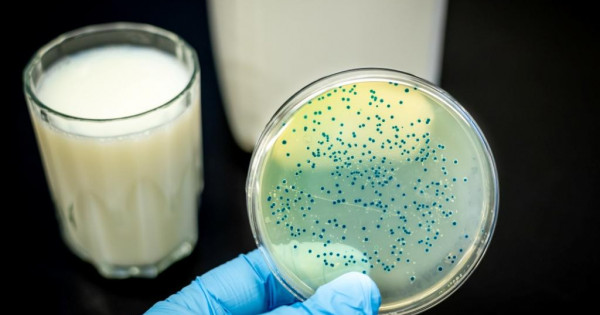

Фото: rr-europe.woah.org
Ғылыми жобаның жетекшісі, ветеринария ғылымдарының докторы, ҚазАТЗУ Микробиология және биотехнология кафедрасының профессоры Айтбай Булашевтың айтуынша, бруцеллезді диагностикалаудың жаңаша әдісінде артықшылықтар бар.
– Отандық құрамдас бөліктерден жасалған жанама гемагглютинация реакциясы-жинағын диагностикалық тәжірибеге енгізу диагностикумның қарапайымдығы мен құнының төмен болуы есебінен ветеринариялық іс-шаралардың тиімділігін едәуір арттырады. Ал әлемдік ветеринариялық тәжірибеде алғаш рет эритроциттік антиген ретінде пайдаланатын рекомбинантты ақуыздар серологиялық зерттеулердің ерекшелігін арттыруға мүмкіндік береді. Бұл әдіс-тәсілдің көмегімен адамға жұққан бруцеллезді диагностикалауға да қолдануға болады, – дейді А.Булашев.
Бруцеллездің диагностикасы жануарлардың басқа да аса қауіпті ауруларының диагностикасы секілді мемлекеттік монополияға кіреді. Сондықтан жанама гемагглютинация реакциясы-жинағының негізгі тұтынушылары – республикалық ветеринариялық зертхана, оның облыстық және аудандық бөлімшелері, сондай-ақ Ауыл шаруашылығы министрлігі ветеринариялық бақылау және қадағалау комитетінің ветеринария жөніндегі ұлттық референттік орталығы.
Жоба нәтижесінде эритроциттердің (қатты фазаның) сыртқы мембрананың жалғыз рекомбинантты ақуыздармен (Omp19, Omp25, Omp31), Brucella тектес бактериялардың периплазмалық кеңістігімен сондай-ақ химерикалық ақуыздармен сенсибилизациясы үшін оңтайлы жағдай жасалған. Жеке ақуыздардан эритроциттік антиген дайындалып, олардың жанама гемагглютинация реакциясы-жинағындағы гомологиялық және гетерологиялық сарысулардағы антигендері зерттелген. Аталған рекомбинантты бруцелла ақуыздарының E. coli-продуценттері штаммдарының бактериялық массасы әзірленген.





































